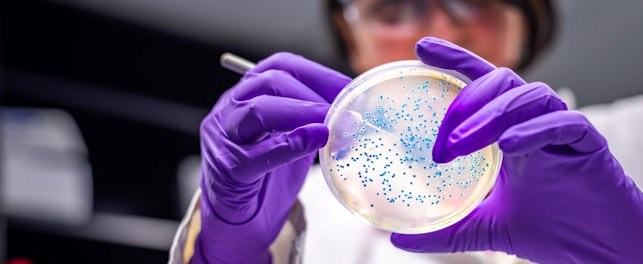
controlo de qualidade de cosméticos

Desde setembro deste ano, passou a ser proibida a comercialização de produtos cosméticos com TPO (Trimethylbenzoyl Diphenylphosphine Oxide) na sua composição, devido à sua classificação como presumivelmente cancerígeno e tóxico para a reprodução.
Este componente, usado para fortalecer o verniz gel nas unhas sob ação da luz LED ou UV, foi integrado na lista de substâncias proibidas nos produtos cosméticos pela Comissão Europeia, com o intuito de reforçar a proteção da saúde pública e assegurar maior segurança na utilização de produtos cosméticos.
Para as marcas e fabricantes, esta mudança envolve a reformulação de produtos que contenham TPO e a atualização da rotulagem, garantindo que a informação comunicada ao consumidor segue os requisitos legais.
Dispomos de uma equipa especializada em cosméticos e produtos de cuidado pessoal, totalmente preparada para dar apoio às empresas neste processo de adaptação, através da verificação técnica de rótulos, análise de ingredientes e avaliação de conformidade regulatória, de acordo com as normas nacionais e europeias.
Descubra como garantir a conformidade dos seus produtos, aqui.
Sobre a SGS
A SGS é a empresa líder mundial em Testes, Inspeção e Certificação. Operamos numa rede de mais de 2.500 laboratórios e escritórios em 115 países, apoiados por uma equipa de 99.500 profissionais dedicados. Com mais de 145 anos de excelência no serviço, combinamos a precisão e exatidão que definem as empresas Suíças para ajudar as organizações a atingir os mais elevados padrões de qualidade, conformidade e sustentabilidade.
A nossa promessa de marca, when you need to be sure, salienta o nosso compromisso com a confiança, integridade e fiabilidade - permitindo às empresas prosperar com certezas. Temos orgulho em oferecer os nossos serviços especializados através do nome SGS e de marcas credíveis e especializadas, incluindo a Brightsight, Bluesign, Maine Pointe e Nutrasource.
A SGS é negociada publicamente na SIX Swiss Exchange sob o símbolo SGSN (ISIN CH1256740924, Reuters SGSN.S, Bloomberg SGSN:SW).
Polo Tecnológico de Lisboa,
Rua Cesina Adães Bermudes 5, Lote 11, 1600-604,
Lisboa,
Portugal